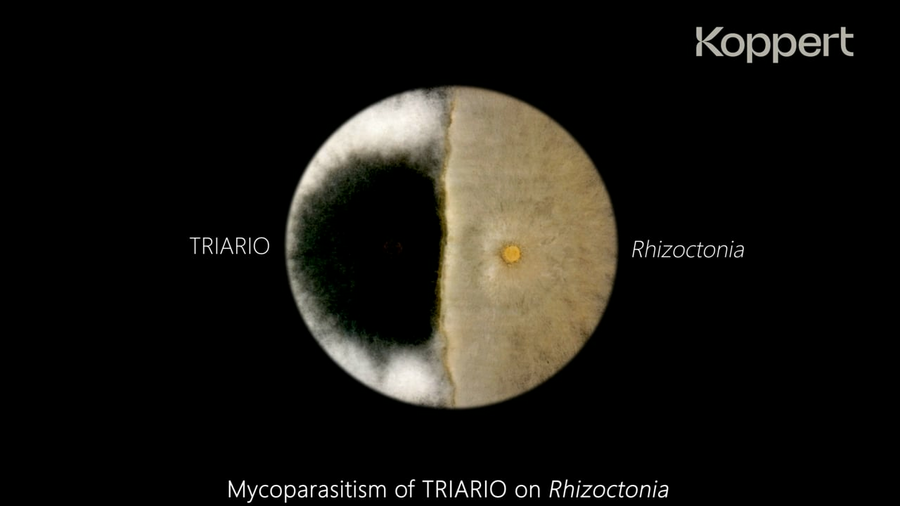
Play Play

Controllo delle malattie del suolo con Triario
Le malattie del suolo come Fusarium, Pythium, Sclerotinia e Rhizoctonia sono problemi in rapida crescita per i coltivatori e causano danni significativi alle colture.
Triario è un biofungicida basato sull'esclusivo fungo Trichoderma harzianum T-22ed è una soluzione naturale per sconfiggere le malattie trasmesse dal terrenoin molte colture a pieno campo come cavolo, cipolla, finocchio, patata, soia, mais e frumento.
Che cos'è Triario?
Triario è un biofungicida versatile che protegge gli apparati radicali delle colture all'aperto dalle malattie trasmesse dal terreno, promuovendo al contempo la crescita, l'uniformità e lo sviluppo delle piante.
Come funziona Triario?
Dopo l'applicazione di Triario all'inizio del ciclo colturale, il fungo stabilisce rapidamente una barriera protettiva intorno alle radici della pianta, superando i patogeni per lo spazio e i nutrienti. Rimane attivo per tutto il ciclo di vita della pianta. Offre quindi vantaggi significativi rispetto ai fungicidi chimici, che rimangono attivi per un periodo di tempo limitato dopo l'applicazione.
Perché utilizzare Triario?
L'uso di Triario nelle colture in pieno campo presenta diversi vantaggi:
-
Controllo delle malattie trasmesse dal suolo
-
Miglioramento dello sviluppo delle radici e della salute della pianta
-
Migliore uniformità del raccolto
-
Facile e sicuro da usare
-
Favorisce l'aumento della resa riducendo la pressione delle malattie
-
Soluzione senza residui
Facile da usare
Triario si applica preferibilmente alla semina o al trapianto, ma può essere applicato durante l'intero ciclo colturale. Triario può essere applicato con attrezzature e sistemi di irrigazione convenzionali e può essere combinato con altri prodotti di uso comune come fertilizzanti, erbicidi e biostimolanti per risparmiare tempo e fatica.
Triario è disponibile in 2 formulazioni: polvere bagnabile (Triario WG) e microgranuli (Triario GR).